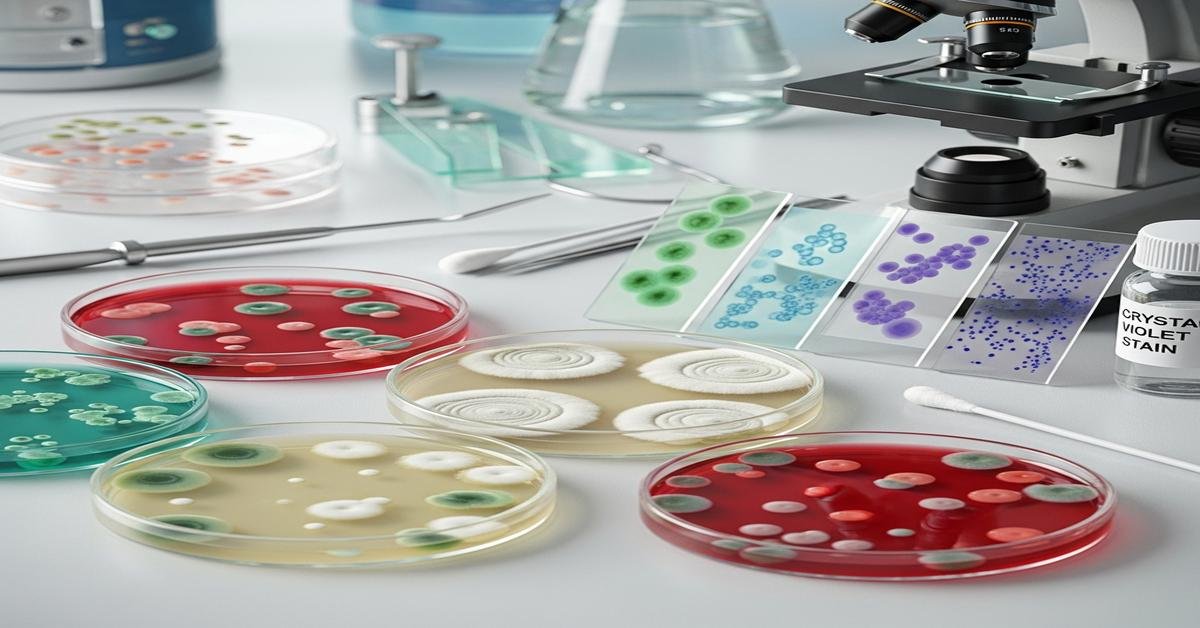
SMB Exam Prep: High-Yield Topics on Bacteriology and Mycology for the Advanced Lab Specialist Exam

The Advanced Lab Specialist exam expects you to think like a bench lead: rapid triage from specimen to result, precise organism ID, and smart interpretation of resistance and biomarkers. This guide distills high-yield bacteriology and mycology topics you are likely to see, and explains the “why” behind each point so you can reason through tricky stems and lab scenarios.
Bacteriology: Start at the Bench, Think to the Report
Workflows matter because they shape what you see. Good answers often reflect correct handling steps.
- Specimen quality drives value. Reject dried or leaking swabs; reject sputum with many epithelial cells; prioritize sterile-site fluids, blood, and tissue. Poor quality inflates contaminants and wastes AST.
- Gram stain is your first decision tool. Match stain to media and safety. Intracellular GN diplococci in urethral exudate = likely N. gonorrhoeae. Pleomorphic GN rods in CSF suggests H. influenzae (needs V/NAD). Branching GP rods raise anaerobe/actinomycete concern. Always explain morphologic clues, not just the organism name.
- Culture conditions are clues. 5% CO₂ for streptococci and H. influenzae. Microaerophilic 42°C for Campylobacter jejuni. BCYE with cysteine for Legionella (no growth on SBA/MAC). Thayer–Martin for N. gonorrhoeae. TCBS for Vibrio. CIN for Yersinia enterocolitica (red “bull’s-eye”). If it only grows with V and X factors, think Haemophilus.
Staphylococci and the D-Test
- ID pathway: GP cocci in clusters → catalase positive → coagulase or latex for S. aureus. S. saprophyticus is novobiocin resistant; S. lugdunensis can be tube coagulase negative yet clinically aggressive (PYR positive).
- MRSA detection: mecA/mecC encode PBP2a → oxacillin/cefoxitin resistance. Cefoxitin disk or PBP2a latex is reliable. mecA PCR confirms. Record as oxacillin-resistant regardless of MIC fluctuation because PBP2a predicts beta-lactam failure.
- D-test logic: Erythromycin R and clindamycin S can hide inducible MLSB resistance. Flattened “D” zone near clindamycin means inducible resistance. Report clindamycin resistant to avoid clinical failure.
Streptococci and Enterococci: Practical Differentiation
- S. pyogenes (Group A): PYR positive, bacitracin susceptible (historical), beta-hemolytic. Why PYR? High specificity; bacitracin misleads with non-GAS.
- S. agalactiae (Group B): CAMP and hippurate positive, narrow beta-hemolysis. In neonates, call fast; in adults, consider polymicrobial wound infections.
- S. pneumoniae: Alpha-hemolytic, optochin susceptible or bile soluble. Why both? Some strains are optochin-intermediate; bile solubility confirms autolysin activity.
- Viridans group strep: Alpha-hemolytic, optochin resistant, often endocarditis in damaged valves. Don’t overcall as S. pneumoniae from sputum.
- Enterococcus: PYR positive, grows in 6.5% NaCl; E. faecalis LAP positive, often ampicillin S; E. faecium often ampicillin R. Screen for VRE (vanA/vanB). High-level gentamicin or streptomycin resistance negates synergy with cell wall agents.
Enterobacterales: Phenotype Shortcuts and Beta-Lactamases
- Lactose fermentation on MAC: Fast pink colonies (e.g., E. coli, Klebsiella) vs. non-lactose fermenters (Shigella, Salmonella, Proteus). E. coli often indole positive, beta-hemolysis on SBA.
- Swarming and urease: Proteus swarms, urease positive, H2S variable. Odor and motility point to deamination reactions.
- ESBLs: Synergy with clavulanate (disk or MIC) confirms. Why important? ESBL predicts cephalosporin failure; report all cephalosporins R even if MIC is low.
- AmpC: Cefoxitin resistance and no clavulanate effect; boronic acid inhibits. Inducible in Enterobacter cloacae complex, Citrobacter freundii, Serratia. Avoid 3rd-gen cephalosporins due to on-therapy derepression.
- Carbapenemases: KPC, NDM, VIM, OXA-48-like, IMP. mCIM detects carbapenemase activity; eCIM discriminates MBLs (EDTA effect). Phenotype matters for therapy and infection control.
Nonfermenters: Recognize Patterns, Know Intrinsic Resistances
- Pseudomonas aeruginosa: Oxidase positive, grape/corn tortilla odor, blue-green pigment, growth at 42°C. Intrinsic to many beta-lactams; check for AMPC overexpression, efflux, and carbapenemases. Avoid reporting tigecycline.
- Acinetobacter baumannii: Oxidase negative coccobacilli. Rapid XDR; sulbactam has intrinsic activity. Colistin may test as only option; confirm with broth microdilution.
- Stenotrophomonas maltophilia: Oxidase negative, DNase positive, intrinsically resistant to carbapenems; TMP-SMX is first-line.
Fastidious and Hazardous Bacteria
- Haemophilus: Needs V (NAD) and sometimes X (hemin). Satellites around S. aureus on SBA. Porphyrin/ALA test detects X-factor independence.
- Neisseria gonorrhoeae: Oxidase positive, glucose fermenter only. Culture on Thayer–Martin; NAAT preferred. Fragile to cold; fast turnaround prevents false negatives.
- Bordetella pertussis: Regan–Lowe media; PCR is superior early. Don’t vortex swabs; it kills organisms and ruins culture yield.
- Legionella pneumophila: BCYE with cysteine; urine antigen detects serogroup 1 only. Respiratory PCR broadens coverage.
- Yersinia enterocolitica: Better at 25–30°C; CIN agar shows bull’s-eye colonies. Urease positive. Cold enrichment explains why it persists in refrigerated foods.
- Brucella and Francisella: Low-dose aerosol risk; handle in BSC. Notify lab if suspected; incubate blood cultures longer. Exam questions probe biosafety choices.
Anaerobes: Clues and Confirmations
- Bacteroides fragilis group: Bile resistant, grows on BBE; hydrolyzes esculin. Almost always beta-lactamase positive; avoid penicillin.
- Clostridioides difficile testing: GDH antigen is sensitive, toxin EIA is specific; two-step algorithm with NAAT resolves discordance. Why? Toxin alone misses cases; NAAT alone overcalls colonization.
- Clostridium perfringens: Double zone hemolysis, lecithinase positive (Nagler). Gas gangrene correlates with rapid growth and toxin production.
- Fusobacterium nucleatum: Slender tapered rods, bread-crumb colonies, chartreuse fluorescence. Linked to Lemierre syndrome; expect beta-lactamase variability.
Mycobacteriology: High-Yield Essentials
- AFB stains: Ziehl–Neelsen or Kinyoun for acid-fast bacilli; auramine–rhodamine is more sensitive for screening. Acid-fastness reflects mycolic acids.
- Culture: MGIT liquid is faster; Lowenstein–Jensen/Solid provides colony morphology and mixed-culture detection. Incubate 35–37°C with CO₂; slow growers need up to 8 weeks.
- NAAT: Detects M. tuberculosis complex directly from smear-positive respiratory samples; helps rule in within hours.
- Safety: BSL-3 work for manipulations that can aerosolize. Rationale: very low infectious dose and airborne transmission.
AST Methods and Interpretation That Win Points
- Methods: Disk diffusion, broth microdilution (gold standard MIC), gradient diffusion (Etest), automated panels. For colistin, only broth microdilution is reliable; disks and Etest are unreliable.
- Intrinsic resistance you must know: Enterococcus to cephalosporins; Stenotrophomonas to carbapenems; Listeria to cephalosporins; Proteus/Providencia/Morganella to colistin and nitrofurantoin; Pseudomonas to many 1st/2nd gen cephalosporins.
- Report logic: ESBLs and carbapenemases trigger cascade reporting and infection control. Don’t report oral cephalosporins on ESBL producers. For H. influenzae, ampicillin S needs beta-lactamase negative or low MIC.
- Screen tests: Nitrocefin for beta-lactamase; cefoxitin screen for MRSA; high-level aminoglycoside screens for enterococci.
Advanced ID: MALDI-TOF, Sequencing, Syndromic Panels
- MALDI-TOF: Fast, accurate to species for most bacteria and yeasts. Limits: Shigella vs enteroinvasive E. coli, some Streptococcus groups, early Candida auris library gaps. Use formic acid extraction for yeasts and filamentous fungi to improve calls.
- 16S/28S/ITS sequencing: Use when MALDI is ambiguous or organism is rare/unusual. The “why”: sequences resolve closely related taxa that share protein spectra.
- PCR panels: Great for CSF and respiratory pathogens. Always correlate with culture because panels can’t do full AST and may pick up colonizers.
Blood Culture Interpretation: Pathogen vs Contaminant
- Time-to-positivity: Fast (≤24 h) with GN rods and S. aureus; slow growth or late positivity with Cutibacterium acnes suggests contamination unless prosthetic material is present.
- Number of sets: Same organism in ≥2 sets = true bacteremia. Single bottle with skin flora = likely contaminant. Break the rule only with strong clinical context (neutropenia, intravascular devices).
- HACEK and nutritionally variant streptococci: Modern systems recover them within standard incubation, but always extend if clinical suspicion is high.
Mycology: Direct Exam First, Then Culture and Antigen
- Direct microscopy saves days. KOH (with or without calcofluor white) clears keratin and highlights chitin. Septate acute-angle hyphae suggest Aspergillus; broad ribbon, pauci-septate hyphae suggest Mucorales; budding yeasts vs pseudohyphae point to Candida species; spherules with endospores in tissue indicate Coccidioides.
- Safety with molds: Do tape preps in a BSC. Dimorphic fungi in mold phase warrant enhanced precautions due to aerosol risk.
Yeasts: Candida, Cryptococcus, and C. auris
- Candida albicans complex: Germ tube positive (C. dubliniensis also can be; confirm with growth at 45°C or MALDI). CHROM media separate common species by colony color. Why care? Species predict resistance (e.g., C. glabrata elevated fluconazole MICs).
- Candida auris: Often misidentified by older systems; MALDI with updated libraries or PCR helps. Multidrug-resistant, survives on surfaces, spreads in healthcare. Flag for infection control and perform colonization screening.
- Cryptococcus neoformans/gattii: Encapsulated yeast. India ink on CSF shows halos; CrAg latex/ELISA is sensitive. Urease positive; brown colonies on Niger seed agar (phenoloxidase). Beware prozone: very high antigen titers can cause false negatives; dilute and retest.
Molds: Aspergillus, Mucorales, and Tough Hyphomycetes
- Aspergillus spp.: Septate hyphae with acute-angle branching. Culture: A. fumigatus has uniseriate phialides covering the upper vesicle; A. niger produces black heads; A. flavus is biseriate with rough conidiophores. Galactomannan (serum/BAL) supports invasive disease; false positives can occur with some antibiotics and foods.
- Mucorales (e.g., Rhizopus, Mucor, Lichtheimia): Rapidly growing, broad ribbon-like hyphae, right-angle branching, few septa. Vascular invasion causes tissue necrosis. Intrinsically resistant to voriconazole; amphotericin B or high-dose posaconazole/isavuconazole are options.
- Scedosporium/Lomentospora and Fusarium: Often resistant to multiple agents. Fusarium can grow in blood cultures and produce canoe-shaped macroconidia. Report promptly; therapy is difficult.
Dermatophytes and Dimorphic Fungi
- Dermatophytes (skin/hair/nails): Trichophyton, Microsporum, Epidermophyton. KOH shows septate hyphae; hair infection may be endothrix (inside shaft) or ectothrix (outside). T. rubrum usually urease negative; T. mentagrophytes urease positive and positive hair perforation test. MALDI now improves speciation.
- Dimorphic fungi: Mold at 25–30°C, yeast (or spherules) at 37°C.
- Histoplasma capsulatum: small intracellular yeasts; urine antigen sensitive for disseminated disease; cross-reacts with other dimorphs.
- Blastomyces dermatitidis: broad-based budding yeasts in tissue; thick walls.
- Coccidioides: spherules with endospores; high lab-acquired infection risk in mold phase; handle in containment.
- Paracoccidioides: “pilot wheel” multiple budding yeast.
- Sporothrix schenckii: cigar-shaped yeasts in tissue; lymphocutaneous spread.
- Talaromyces (Penicillium) marneffei: yeast-like cells with transverse septa in tissue; endemic to Southeast Asia.
Fungal Antigen and Biomarker Interpretation
- Beta-D-glucan (BDG): Broad marker for invasive fungal infections (not Cryptococcus or Mucorales). False positives: hemodialysis with cellulose membranes, IVIG, severe mucositis, gauze exposure, some antibiotics. Use trends and pretest probability.
- Galactomannan (GM): Supports invasive aspergillosis, especially in BAL. False positives from some antibiotics and foods; false negatives after mold-active prophylaxis.
- Cryptococcal antigen: Very sensitive in CSF and serum. Watch for prozone; dilute if clinical suspicion is high but test is negative.
Antifungal Susceptibility: When and What It Means
- Methods: CLSI broth microdilution (M27 yeasts, M38 molds) is the reference. Gradient diffusion works for many but not all species-drug pairs. Breakpoints exist for common yeasts; for molds we often use epidemiologic cutoff values (ECVs) to flag non-wild-type isolates.
- Predictable patterns: C. glabrata often dose-dependent to fluconazole; consider high-dose or echinocandin. C. parapsilosis has higher echinocandin MICs; correlate with site and response. Aspergillus terreus is amphotericin B resistant. Mucorales are resistant to voriconazole. Scedosporium/Lomentospora show multidrug resistance.
- Mechanisms matter: Azole resistance via ERG11 mutations and efflux pumps; echinocandin resistance via FKS hot-spot mutations; amphotericin resistance via altered ergosterol content. Mechanism predicts cross-resistance within drug classes.
Quality and Safety Points the Exam Loves
- Biosafety: Manipulate potential dimorphic molds and Brucella/Francisella in a BSC; minimize aerosols. No sniffing plates. Tape preps only in containment.
- QC that signals competence: Use appropriate control organisms for media (e.g., lactose fermenter and nonfermenter on MAC), oxidase reagent daily checks, AST lot verification with QC strains, and temperature/CO₂ logs.
- Contamination control: Blood culture contaminant rate should be low (generally <3%). Swab to plate in under 2 hours if possible, or use transport media designed for delay.
- Result language: Add interpretive comments when needed (e.g., “ESBL detected; cephalosporins are not recommended” or “C. auris identified; infection control notified”). The “why”: it changes patient care and signals your expertise.
Common Exam Pitfalls and How to Avoid Them
- Confusing colonization with infection. Positive PCR for C. difficile toxin gene without toxin by EIA and no symptoms should not drive therapy. Justify with algorithm logic.
- Forgetting intrinsic resistance. Reporting ceftriaxone for Enterococcus or clindamycin for inducible MLSB is a red flag.
- Overreliance on one test. A negative GM does not exclude aspergillosis on mold-active prophylaxis. Explain pretest probability and combination testing.
- Misreading morphology. Broad, right-angle hyphae are Mucorales, not Aspergillus. That mistake changes drug choice from voriconazole to amphotericin.
- Ignoring safety cues. Opening a plate with fluffy white mold from a desert traveler without a BSC screams Coccidioides exposure risk.
Rapid Recall: Bench Clues to Lock In
- BCYE growth only → think Legionella.
- Germ tube positive yeast → likely C. albicans/dubliniensis.
- Optochin susceptible and bile soluble → S. pneumoniae.
- Inducible clindamycin R (D-test) → report clindamycin resistant.
- Cefoxitin resistant E. coli, clavulanate no effect → AmpC likely.
- Urease positive, swarming GN rod → Proteus.
- India ink halo and positive CrAg → Cryptococcus.
- Right-angle, broad hyphae on KOH → Mucorales.
- Urine Histo Ag positive in AIDS patient with cytopenias → probable disseminated histoplasmosis.
Study with the bench workflow in mind. Ask what the specimen tells you, what the first stains and plates suggest, and which safety and interpretive decisions follow. The exam rewards that practical chain of reasoning as much as it rewards memorized lists.